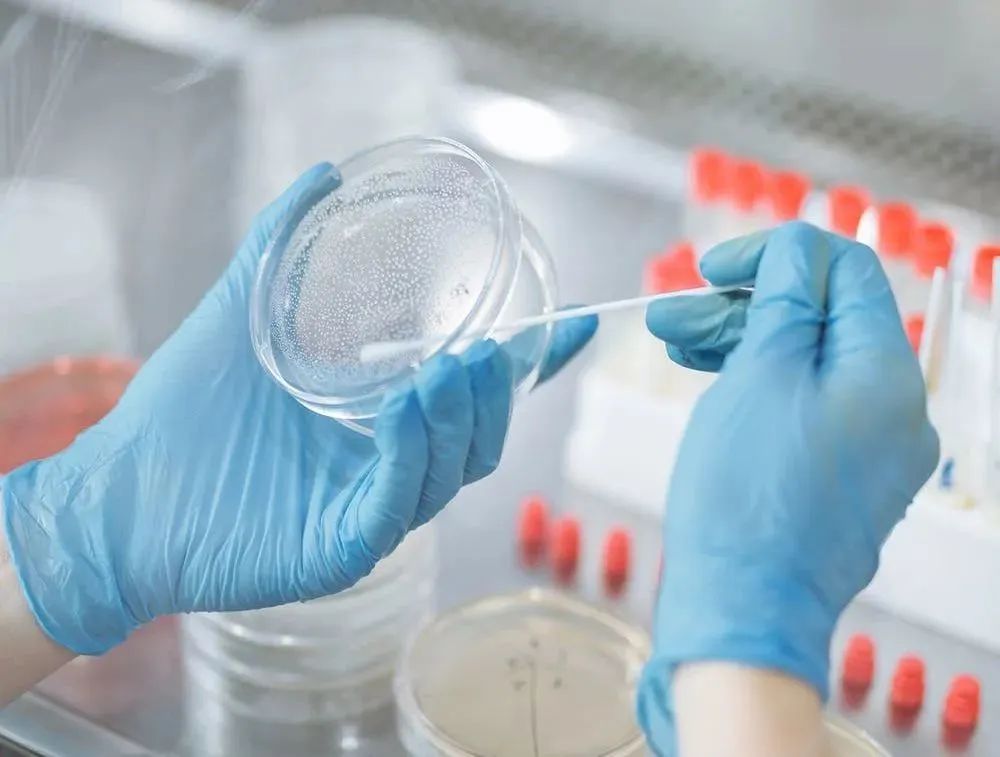

合成生物产业迎来历史发展机遇,应用领域迅猛拓展,在全球保持较高的速度增长。广泛应用于医疗健康、能源、材料、化工、农业、食品、消费品等诸多领域。随着核心技术不断进步,行业规模将进一步迅速扩张。
围绕合成生物学产业领域的学、研、产、投等全链条,2022年5月30日, 未名科创携手小饭桌、北京大学校友青年CEO俱乐部、北大研究生会以线上直播方式共同主办了第一期未名科创汇行业沙龙,共同探讨合成生物赛道的产业发展与投资趋势。
华纳创新科技有限公司CEO胡运兴、一兮生物创始人刘振云、芯宿科技联合创始人兼 CEO赵昕、芯宿科技合伙人董一名、未名拾光创始人赵亚冉、凡卓资本副总裁周怡、碧桂园创投张伟力等多位业内校友嘉宾,以行业一线的独家视野,从技术研发、项目落地、产业投资以及生态合作等多角度,介绍合成生物学走出实验室、走向产业化的路径,共同探讨合成生物赛道的产业发展与投资趋势。

沙龙嘉宾
一、合成生物学是新兴的交叉学科,是引领未来的方向
本科毕业于北京大学合成生物学专业的胡运兴,目前是华纳创新科技有限公司CEO,在高通量合成化学方面积累了丰富的经验。他指出,合成生物学是新兴的交叉学科,是未来的方向。
作为一门前沿交叉学科,合成生物学汇聚并融合了生命科学、工程学、基因组学、信息学、数学、化学、计算机科学等诸多学科。

总体来说,北京大学合成生物学及相关学科专业和科研实力在国内数一数二。在北大,生物学问题的基础研究,已经发展成了多学科交叉专业,其中有与数学交叉的定量生物学;与计算机交叉的生物信息学;与工学交叉的合成生物学;与农学交叉的植物生物学;与化学交叉的化学生物学;与物理交叉的结构生物学;此外还有与医学交叉和心理学交叉的学科。

曾就读于北京大学前沿交叉学科研究院的董一名,主要从事生物和其他学科的交叉研究。
生物学和其他学科交叉,包括许多方向,也有许多知名老师,其中以欧阳颀院士为代表的非线性科学与生物物理学家,在非线性动力学实验研究中发现了一系列螺旋波失稳现象并对其机理作出理论解释,并将非线性科学方法运用于系统生物学与合成生物学研究。
北京大学硬件设施在国内也是屈指可数,生物科学研究场所遍布北大本部,其中有金光生命科学大楼,主要的学术报告和公共仪器平台都在这里;还有生物技术楼以及大型实验动物中心等,在合成生物学科研方面为众多学子创造了条件。

当前,资源短缺、环境污染、气候变化等全球问题日益凸显,合成生物学为实现“社会—生态环境—经济”和谐发展提供了发展路径。
与此同时,合成生物学也有望催生下一次生物技术革命。目前,科研机构及科研人员已经不局限于进行基因剪接,而是开始构建遗传密码,以期利用合成的遗传因子构建新的生物体。
国际上的合成生物学研究也在飞速发展,近年来已经逐渐成为国内外各大院校的热门专业,越来越多的学子、创投人员、企业和资本都开始关注这一行业的发展趋势。
二、科研与产业互动,加速合成生物科研成果转化
合成生物学广义上是指通过构建生物功能元件、装置和系统,对细胞或生命体进行遗传学设计、改造,使其拥有满足人类需求的生物功能,甚至创造新的生物系统。
“建物致知、建物致用”是合成生物学的两大愿景,也就是通过建造生物体系而了解生命、通过创造生物体系来服务社会。
华纳创新科技有限公司从2017年开始和北大、中科院等单位合作,自主研发的高通量软硬件平台,包括机械设计、电气设计、单片机实验设计及数据处理软件等相关项目。其中在高通量共沉淀法催化剂制备、钙钛矿薄膜制备、分子间作用力分析、核酸筛选等项目参加了国家重点研发计划。高通量筛选系统综合了软硬件、数据处理与分析应用目前都处于技术前沿,未来发展前景广阔。

依托于北京大学蛋白质与植物基因研究国家重点实验室、清华大学工业生物催化教育部重点实验室,未名拾光生物科技公司专注医美、护肤创新原料开发和生产。目前自主研发了高通量筛选、仿生设计和生物合成三大平台,主要致力于从自然界中寻找天然的生物活性成分,经过结构优化设计,最终通过生物反应器完成原料产出,为下游客户提供绿色、安全、有效的全应用场景功能性原料。

创建于2019年的一兮生物,主要致力于合成生物学技术研发,开发的HMO产品已在产业化阶段,为国内最早实现产业化的合成生物学产品之一。此外,还有开发分子芯片驱动生物技术半导体化,利用DNA、RNA、蛋白的高通量合成与检测功能,推动合成生物、生物医药、DNA信息存储应用的芯宿科技公司。
这些公司通过自身科研实力,借助北大资源,将科研与产业互动,最终加速合成生物科研成果转化。
合成生物学系多学科融合,科研成果与产业结合将有望形成颠覆性生物技术创新,为破解人类社会面临的资源与环境不足的重大挑战提供全新的解决方案。
三、合成生物产业蓬勃发展,市场空间广阔
合成生物学按照特定目标理性设计、改造乃至从头重新合成生物体系,用以解决人类食品缺乏、能源紧缺、环境污染、医疗健康等各方面的问题,对于全球可持续发展至关重要。
根据CBInsights分析数据显示,预计到2024年合成生物学市场规模将达189亿美元,2019-2024年复合增长率达28.8%。

合成生物制造过程兼具绿色环保与降本增效优势,生物技术的应用可以降低工业过程能耗、原料消耗、减少空气污染、水污染。
据世界自然基金会预估,到2030年工业生物技术每年将可降低10亿至25亿吨二氧化碳排放。
从产业链上下游角度来划分,上游为各类技术赋能公司,下游为各类产品应用型公司。
就上游来看,董一名表示,做学科交叉过程,可以更好的去理解生物系统、解决生物问题。例如DNA储存、测序、合成、基因编辑以及理论预测等生物合成所必须的技术能力,都是需要不断进行革新的,只有不断进行技术升级,才能构建起底层技术壁垒,更好地服务于相关的市场领域。
从下游来看,相比化工等其他领域,赵亚冉指出,合成生物在医疗领域的应用有非常明显的优势,相关市场逻辑就是寻找与药品接近的场景,然后从医药下沉,往消费品迁移。因为医疗领域可以带来高附加值,高附加值可以为产业落地创造一个大的缓冲空间。未名拾光做的一些产品,包括胶原蛋白在护肤的应用,在医美的应用,都具有非常大的市场前景。

从投资角度来看,张伟力表示,投资者与创业者面临的问题有很大的区别,投资人更关注团队是否具备核心技术与持续研发能力;核心产品所在细分领域的市场空间、产品性能、成本等核心竞争优势以及生产出来的产品是否足够刚性等;另外还要考虑国家政策因素以及国内供应链是否完备,这些都是投资人所看重的方面。
从研发到成果转化,再到规模化生产,最终实现产业化,所创造的产品能够最终造福社会,上下游整个产业链的每个环节,实际操作起来都是一个艰难而复杂的过程。虽然风险很大,但在市场利益驱使下,必将吸引更多创投人员和企业前赴后继进入这一行业。
四、行业大咖给创业者的忠告
在过去一年多时间里,合成生物学无疑是一级市场中最受关注的火爆赛道,巨额融资频现,海外多家合成生物学公司接连上市。
合成生物学高潜力和颠覆性的特点让其掀起新一波投资与创业的浪潮。
虽然行业前景和资本市场火爆,但嘉宾们也普遍将自己在创业中遇到的问题和瓶颈进行了交流。
合成生物学每年都有大量专利申请下来,但大部分专利真正落地的非常少。究其原因,刘振云表示,一方面是缺少能够落地的人才。
传统生物制造已经经历了很长时间,其中包括酿酒工艺、味精生产工艺等,这些从事传统行业的人员,很少能够理解高校、科研机构、科学家等从象牙塔里做出来科研成果,由于存在这种上下理解和沟通上的错位,让很多科研成果到产业工人这里就难以落地,最终也很难走向产业化。
另一方面,科研人员在做研发时,没有做好底层设计。从研发到落地,真正到产品做出来,需要考虑多个环节,包括工艺流程设计、建厂、产品生产、市场开拓、产业化,缺少任何一环都很难产生经济效益。
除了以上原因,刘振云认为,合成生物学作为未来的重点发展方向之一的产业化,短缺的关键人才是一个需要长期培养的过程。
为了实现产业化,前期投入成本也非常高。赵亚冉表示,从实验室到工厂,实现产业化遇到每个问题,以及解决这些问题,都意味着成本增加。对于初创公司来说,人才和资金基本就是这个公司能否生存下来的核心能力。

如何在创业过程中避免入坑,大咖们也纷纷给出了自己的建议:
除了一些基础的创业能力外,创业者首先应具备稳定的心态,只有心态稳才能应对外界的干扰,朝着选对的方向不断前进,最终做出一个高价值的产业公司;其次要选对适合自己的创业城市,因为这个城市将关乎到今后创业中招人和资金的来源,因为人和钱是创业者一个非常重要的方面;最后需要解决创业中的遇到的各种问题,就是要在乐观中保持谨慎。再大的困难,只要只要去努力,总是能够解决的。

作为北大校友创新创业与科技成果转化的综合性孵化平台,未名科创也将积极整合资源,聚集北大优质科技人才,面向北大有科技类创业意向的学生、校友等,为大家提供专业、精准、高质量的创业公开课和行业沙龙。
分享真知灼见、提升创业基础认知、打下创业基础,走好创业第一步,实现集科研、资本、产业等多方位创投生态全周期陪伴成长。
点击查看原文